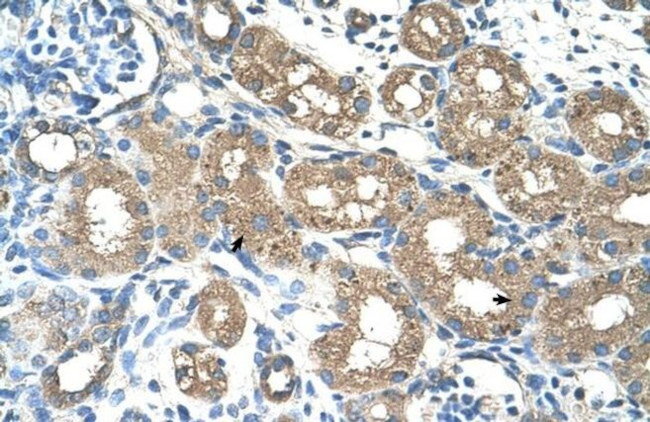
ALAS2 Antibody in Immunohistochemistry (Paraffin) (IHC (P))

Search
Invitrogen
ALAS2 Polyclonal Antibody
{{$productOrderCtrl.translations['antibody.pdp.commerceCard.promotion.promotions']}}
{{$productOrderCtrl.translations['antibody.pdp.commerceCard.promotion.viewpromo']}}
{{$productOrderCtrl.translations['antibody.pdp.commerceCard.promotion.promocode']}}: {{promo.promoCode}} {{promo.promoTitle}} {{promo.promoDescription}}. {{$productOrderCtrl.translations['antibody.pdp.commerceCard.promotion.learnmore']}}
产品信息
PA5-42079
种属反应
宿主/亚型
分类
类型
抗原
偶联物
形式
浓度
规格
纯化类型
保存液
内含物
保存条件
运输条件
RRID
产品详细信息
Peptide sequence: VFKTVNRWAD AYPFAQHFSE ASVASKDVSV WCSNDYLGMS RHPQVLQATQ
Sequence homology: Cow: 86%; Dog: 93%; Guinea Pig: 93%; Horse: 93%; Human: 100%; Mouse: 93%; Rabbit: 93%; Rat: 93%
靶标信息
ALAS2 specifies an erythroid-specific mitochondrially located enzyme. It catalyzes the first step in the heme biosynthetic pathway. Defects in this gene cause X-linked pyridoxine-responsive sideroblastic anemia.The product of this gene specifies an erythroid-specific mitochondrially located enzyme. The encoded protein catalyzes the first step in the heme biosynthetic pathway. Defects in this gene cause X-linked pyridoxine-responsive sideroblastic anemia. Alternatively spliced transcript variants encoding different isoforms have been identified.
仅用于科研。不用于诊断过程。未经明确授权不得转售。
篇参考文献 (0)
生物信息学
蛋白别名: 5-aminolevulinate synthase, erythroid-specific, mitochondrial; 5-aminolevulinic acid synthase 2; ALAS-E; aminolevulinate, delta-, synthase 2; Delta-ALA synthase 2; delta-ALA synthetase; Delta-aminolevulinate synthase 2; erythroid-specific delta-aminolevulinate synthase; PRO2399; RP5-884M20.1; unnamed protein product
基因别名: ALAS-E; ALAS2; ALASE; ANH1; ASB; SIDBA1; XLDPP; XLEPP; XLSA
UniProt ID: (Human) P22557
Entrez Gene ID: (Human) 212